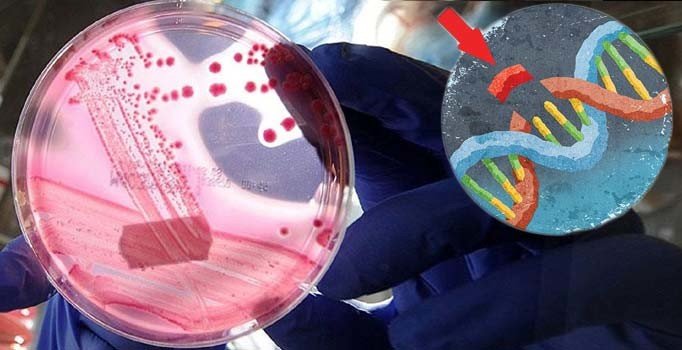
ABD'li doktorlar ilk kez genlerde düzenleme yaptı

Popsci.com sitesinin haberine göre; doktorlar bu tedavide hastanın iliğinden kök hücreleri alarak CRISPR tekniği ile düzgün bir kırmızı kan hücresi üretimi sağlanması için DNA’larında düzenleme yaptı.
Orak hücre anemisi, genlerde meydana gelen bozukluk sonucu, normalde yuvarlak şekilli olan kırmızı kan hücrelerinin orak şeklinde olmaları nedeni ile küçük kan damarlarını tıkayarak oksijen taşıma ve dokuları besleme görevini yapamamaları sonucunu doğuran genetik bir hastalık.
Tedavisi mümkün olmayan bu hastalık şiddetli ağrılı krizlere neden olmakla birlikte zatüre, karaciğer büyümesi, safra kesesinde taş, kalça kemiği erimesi, iskelet siteminde bozukluk, felç gibi durumlara yol açabiliyor.
TEDAVİ İHTİMALİ YÜZDE 90
Habere göre bu hastalıkta kan değişimi tedavisi sadece hastaların yüzde 10’unda işe yarıyor. Ancak doktorların hastaya uyguladığı tedavinin başarılı olması durumunda orak hücre anemisi hastalarının yüzde 90’ı bu şekilde tedavi edilebilecek.
41 yaşındaki Victoria Gray, ABD’de CRISPR tekniği ile hücreleri düzenlenen ilk hasta oldu.
Kısaca gen düzenlemesi olarak bilinen CRISPR ilk kez Çinli bir doktor tarafından denenmişti. He Jiankui bu tekniği insan embriyolarını düzenlemek içi kullanmıştı.
Düzenlenmiş embriyoları anne rahmine yerleştiren doktor, AIDS’e karşı direnç gösteren CCR5 genini etkisiz hale getirmeyi amaçlamıştı. Ancak doktorun uygulaması ahlaki bulunmamış ve hakkında yasal işlem başlatılmıştı.